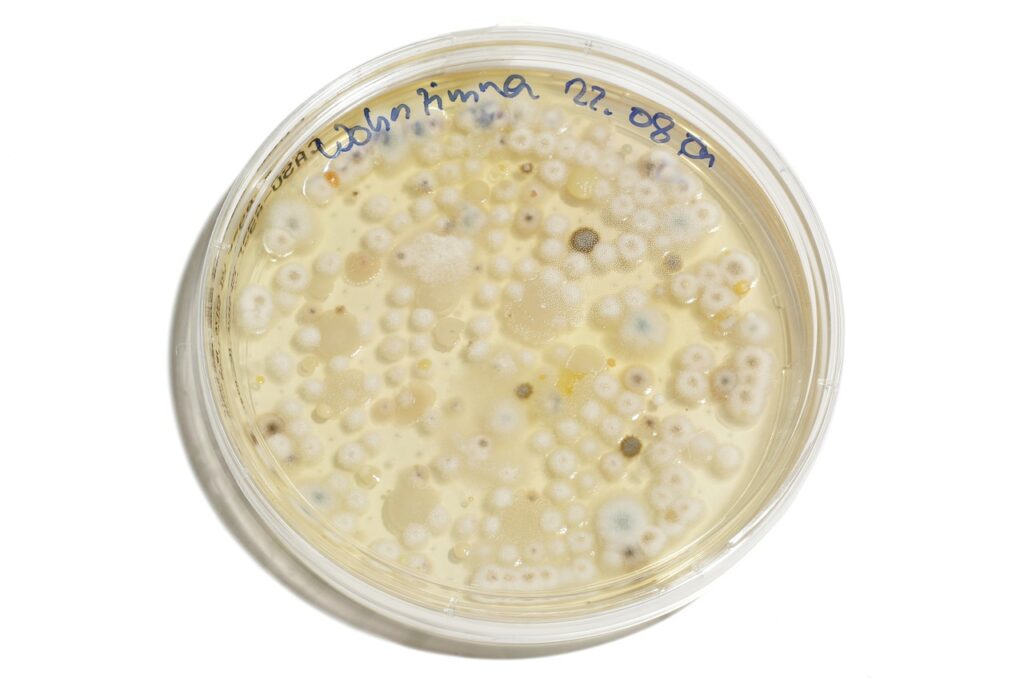
bacteria

86 Curious Facts About Bacteria You Need to Know
Facts About Bacteria
Although many people feel nervous when they hear the term bacteria, countless facts about bacteria reveal a far more complex and fascinating reality. As one of the very earliest organisms on planet earth, bacteria have shaped ecosystems, influenced human evolution, and continue to affect daily life in surprising ways.
Because microscopic organisms are often misunderstood, a deeper explanation is needed to help readers feel confident rather than afraid. Moreover, empathy is felt for anyone who has experienced various bacterial infections, food poisoning, or concerns about harmful bacteria, since uncertainty often creates unnecessary worry.
Interestingly, numerous facts about bacteria show that they are not only everywhere but also essential for survival. Although some pathogenic bacteria cause fatal diseases, many others serve as a great source of antibiotics, assist the immune system, support the digestive system, and act as a crucial part of the ecosystem.
Additionally, scientific discoveries about the study of bacteria continue to provide advancements in the pharmaceutical industry, public health, and even production of a wide variety of chemotherapeutics.
Consequently, curiosity about facts about bacteria has steadily increased. Because the average person interacts with bacterial species daily—on the skin, in the mouth, inside the intestinal tract, and even on a kitchen sponge—an accessible and authoritative guide is needed.
Furthermore, understanding the relationship between good bacteria, gut bacteria, and overall wellness helps reduce fear, especially when dealing with topics such as urinary tract infections, skin infection, or e. coli infection.
What Makes Bacteria So Unique? Essential Facts About Bacteria

Bacteria Are Among the Earliest Forms of Life
Surprisingly, one of the most powerful facts about bacteria is that they are believed to be among the earliest forms of life on earth. Moreover, these unicellular organisms evolved long before plants, animals, or fungi existed.
Because bacteria thrive in extreme conditions, they can be found in locations as varied as hot springs, deep-sea vents, glaciers, and even inside human body parts.
Additionally, the dutch scientist Antonie van Leeuwenhoek—often called the father of microbiology—first observed bacteria in pond water, using lenses he crafted himself.
Later, he and the dutch microscopist Antonie van Leeuwenhoek helped establish the foundations for the study of bacteria, even though the singular word “bacterium” came from a Greek word meaning “small stick,” possibly referring to the shape of bacteria seen under his microscope.
Understanding Bacterial Structure: Facts About Bacteria That Explain Their Power
Bacteria Are Unicellular Organisms Without a True Nucleus
Additionally, important facts about bacteria highlight their simple structure. Because they lack a true nucleus, their genetic material is found in a single bacterial chromosome that floats freely within the cell. Moreover, bacteria possess cell walls, a membrane, and often structures used for movement.
Bacterial Shapes Reveal Their Behavior
Interestingly, different types of bacteria display different shapes, including:
- Rod-shaped (bacilli)
- Sphere-shaped (cocci)
- Spiral-shaped (spirilla)
Furthermore, these shapes can influence how bacteria move, reproduce, or cause disease. Additionally, size varies widely; sometimes the body length or length of a complete bacteria is so tiny that even millions of bacteria cannot be seen with the naked eye, even though they form a colony of bacterial cells.
How Bacteria Survive and Thrive: More Facts About Bacteria

Bacteria Adapt Through Random Mutations
Interestingly, countless facts about bacteria explain their remarkable adaptability. Moreover, bacteria evolve quickly because random mutations occur during cell division. Because millions of bacteria can multiply in hours, mutations spread rapidly through a population.
Additionally, these changes sometimes create bacterial resistance, especially when antibiotics are overused. Consequently, antibiotic resistance becomes a major concern for public health, since infections caused by resistant strains require more complex treatments.
Furthermore, the rise of methicillin-resistant staphylococcus aureus, often known as MRSA, demonstrates how serious resistant pathogens can become. Although many bacteria remain harmless, this pathogen—disease-causing bacteria creates severe skin infection and other medical complications.
Because MRSA spreads in hospitals, gyms, and crowded environments, health professionals remain vigilant, using updated medical records and strict hygiene protocols.
Different Types of Bacteria Serve Different Purposes
Additionally, facts about bacteria emphasize that not all bacteria are dangerous. Although some are harmful, many bacterial species support life in incredible ways. For example:
- Good bacteria help digest food.
- Soil bacteria break down dead plants.
- Some bacteria help produce amino acids and vitamins.
- Others work as biocontrol agents against pests.
Moreover, bacteria are deeply involved in various applications of bacteria, including agriculture, environmental protection, and food processing. Because they can survive high pressures, freezing temperatures, and extreme heat, bacteria play a primary role in balancing ecosystems.
Gram-Positive and Gram-Negative Bacteria
Interestingly, one essential concept in the study of bacterial species is the gram stain, which separates bacteria into gram-positive bacteria and gram-negative bacteria. Because their cell walls differ in structure, the stain helps scientists identify diseases and choose the best way to treat infections.
- Gram-positive bacteria have thick cell walls and are represented by an entire group of gram-positive bacteria such as Staphylococcus and Streptococcus.
- Gram-negative bacteria have thinner walls but stronger resistance, including species like escherichia coli, Salmonella, and others.
Consequently, understanding these distinctions helps diagnose various bacterial infections, control outbreaks, and protect vulnerable populations.
Where Bacteria Live: Surprising Facts About Bacteria

The Human Body Contains More Bacteria Than Human Cells
Surprisingly, one of the most impressive facts about bacteria is that trillions of them live inside the human body.
Moreover, estimates suggest that bacteria cells may outnumber human cells, especially in the intestinal tract and on the skin. Because of this relationship, the human body functions as a shared environment where both humans and microbes coexist.
Furthermore, gut bacteria assist the immune system, protect against invading pathogens, help produce vitamins, and support mental well-being. Additionally, researchers believe that conditions like inflammation, allergies, and anxiety may be connected to imbalances in gut microbes.
Bacteria Exist on Every Human Body Surface
Interestingly, diverse bacterial species occupy nearly all human body parts, including the mouth, scalp, hands, and even belly buttons. Moreover, certain microbes grow on human hair, feeding on natural oils. Because people differ genetically and environmentally, each person carries a unique microbial fingerprint.
Additionally, scientific studies have shown that even the smell of rain comes from soil bacteria releasing a compound called geosmin. Consequently, this everyday scent becomes part of the fascinating list of facts about bacteria that influence the human experience.
Bacteria in Daily Life: More Facts About Bacteria That Affect You

Bacteria Are Found in Foods, Homes, and Everyday Environments
Surprisingly, many facts about bacteria show that they live all around us—on surfaces, in air, and inside household items. Moreover, one surprising discovery revealed that an ordinary kitchen sponge may contain more bacterial species than a bathroom surface.
Because moisture and leftover food particles create an ideal energy source, bacteria rapidly multiply in these environments.
Additionally, bacteria contribute positively to daily life. Because they assist in fermenting foods, they support the creation of yogurt, cheese, sauerkraut, and kombucha.
Furthermore, bacteria are essential in beverage industries, helping produce beer, wine, and vinegar. Consequently, what many people enjoy as flavorful food or drink often depends on bacterial processes.
Bacteria Influence Weather, Ecosystems, and Natural Cycles
Interestingly, surprising facts about bacteria reveal their influence on natural systems. Moreover, certain bacteria help regulate nitrogen in soil, assisting plants in getting essential nutrients. Because bacteria break down dead plants and organic matter, they recycle carbon, nitrogen, and other elements back into the environment.
Additionally, bacteria contribute to the production of gases such as carbon dioxide, affecting atmospheric cycles. Furthermore, these microorganisms remain a crucial part of the ecosystem, supporting plant growth, maintaining soil health, and powering nutrient cycles that sustain life.
Consequently, understanding these facts about bacteria helps people appreciate the invisible processes that protect forests, oceans, and farmland.
Strange and Interesting Facts About Bacteria
Some Bacteria Glow, Communicate, and Produce Electrical Signals
Interestingly, many facts about bacteria reveal behaviors once thought impossible for microorganisms. Moreover, some bacteria produce light through bioluminescence, making certain marine creatures glow in the dark. Because these microscopic organisms communicate using chemical signals—a process called quorum sensing—they coordinate movement, reproduction, and defense.
Additionally, specific bacterial species create electrical signals, allowing them to transfer energy between cells. Furthermore, researchers believe these abilities may be used one day in biotechnology, environmental cleanup, or energy production.
Bacteria Can Survive High Temperatures and Extreme Environments
Surprisingly, numerous bacteria thrive in extreme heat, cold, radiation, and pressure. Moreover, bacteria living in hot springs survive temperatures above 160°F (70°C), demonstrating resilience unmatched by most organisms.
Because they evolved to use unusual energy sources—such as sulfur, methane, or sunlight—these microbes offer valuable insights into how life might exist on other planets.
Additionally, extremophiles provide essential enzymes used by the pharmaceutical industry and DNA technology. Consequently, these facts about bacteria show that extreme environments are not empty wastelands but vibrant ecosystems powered by hardy microorganisms.
The Relationship Between Humans and Bacteria

Good Bacteria Protect the Body
Interestingly, countless facts about bacteria highlight the protective power of beneficial microbes. Moreover, good bacteria strengthen the immune system, prevent invading pathogens, and support metabolism. Because probiotic supplement use has increased, many people now understand the connection between gut microbes and overall well-being.
Additionally, probiotics help restore balance after illness, stress, or antibiotic treatment. Furthermore, these microbes assist with digestion, mood regulation, and inflammation control.
Harmful Bacteria Still Pose Serious Risks
Although many bacteria are beneficial, some remain dangerous. Moreover, pathogenic bacteria cause contagious bacterial disease, urinary tract infections, pneumonia, and fatal diseases. Because infections spread through contact, contaminated food, or surfaces, proper hygiene and awareness remain essential.
Additionally, the united states reports millions of bacterial illnesses yearly, from the common cold (which is viral but often complicated by bacteria) to severe foodborne outbreaks like those caused by escherichia coli. Furthermore, timely treatment and accurate diagnosis depend heavily on updated research, laboratory tools, and preventive public-health strategies.
Could you give this article a read when you can? Facts About the Urinary System You Should Know. It offers some additional insights on the topic.
How Bacteria Are Studied: Scientific Facts About Bacteria
Modern Tools Reveal the Hidden World of Microbes
Interestingly, many facts about bacteria show how advanced technology has transformed the way microbes are observed.
Moreover, modern microscopes allow scientists to view bacterial structures with remarkable clarity, even though the organisms are unseen by the naked eye. Because specialized lenses and digital imaging are used, details such as scale bars, cell walls, and genetic material can now be measured precisely.
Additionally, scientists examine bacteria to identify different types of bacteria, understand the type of bacteria causing illness, and study their evolutionary relationships.
Furthermore, samples from soil, water, and human tissues reveal how bacteria interact with the environment, the human body, and other microorganisms. Consequently, the study of bacteria has become essential for medicine, agriculture, and biotechnology.
Bacteria Have a Major Role in Medical Science
Interestingly, many facts about bacteria reveal that microbes are far more important to medicine than most people realize. Moreover, bacteria were responsible for the discovery of penicillin—one of the greatest medical breakthroughs in history.
Because bacterial competition naturally produces antibiotic compounds, they became a great source of antibiotics used worldwide.
Additionally, bacteria are involved in the production of a wide variety of chemotherapeutics, vaccines, and diagnostic tools. Furthermore, cutting-edge research uses bacterial enzymes in genetic engineering and biotechnology.
Consequently, facts about bacteria demonstrate how these minute organisms influence nearly every aspect of health and science.
Unusual Places Where Bacteria Live: More Facts About Bacteria

Bacteria Exist in Places Humans Rarely Consider
Surprisingly, many facts about bacteria show that they thrive in unexpected places. Moreover, bacteria live in glaciers, deserts, radioactive waste, and deep underground environments where no sunlight reaches. Because they use diverse energy sources, different bacterial species survive where animals and plants cannot.
Additionally, bacteria have been found on the International Space Station, confirming their ability to withstand challenging conditions.
Furthermore, some microbes survive extreme dryness and radiation, raising questions about how the earliest forms of life persisted on ancient Earth. Consequently, bacteria remain essential clues in the search for life beyond our planet.
Bacteria Are Found in Animals, Insects, and Small Creatures
Interestingly, various facts about bacteria highlight their presence inside nearly every small animal, insect, and plant. Moreover, bacteria living inside insects often provide nutrients or help digest food. Because microbes influence behavior, immunity, and survival, they are essential partners in the natural world.
Additionally, animals such as cows, birds, and reptiles depend on bacteria to break down complex plant fibers. Furthermore, marine creatures—including corals and sponges—host bacterial communities that support ocean ecosystems. Consequently, understanding these facts about bacteria helps explain how interconnected all life truly is.
Bacteria and Food Safety
How Bacteria Cause Food Poisoning
Interestingly, essential facts about bacteria reveal that microbes cause many global cases of food poisoning. Moreover, illnesses occur when harmful bacteria—such as Salmonella or escherichia coli—contaminate raw meat, unwashed produce, or kitchen tools.
Because these bacteria multiply quickly in warm environments, improper storage increases risk.
Additionally, symptoms such as vomiting, diarrhea, and fever often indicate exposure to bacteria. Furthermore, outbreaks can spread rapidly in restaurants, schools, or communities if sanitation rules are not followed. Consequently, learning facts about bacteria helps people reduce risks in everyday cooking.
Preventing Bacterial Contamination
Moreover, best practices for avoiding foodborne illness include:
- Keeping raw meats separate from produce.
- Washing hands and tools frequently.
- Cooking foods to safe temperatures.
- Refrigerating leftovers promptly.
- Avoiding cross-contamination on surfaces.
Additionally, understanding the best way to limit bacterial growth creates safer kitchens and healthier families. Furthermore, public awareness campaigns in the united states and worldwide emphasize these strategies to protect communities.
How Bacteria Impact Human Health: Deeper Facts About Bacteria

Bacteria Inside the Digestive System
Interestingly, many facts about bacteria highlight how deeply microbes influence human wellness. Moreover, the digestive system depends on trillions of bacteria to break down food, extract nutrients, and produce essential vitamins. Because these microorganisms assist with metabolism and immune defense, they form one of the most important biological partnerships inside the human body.
Additionally, science shows that gut microbes help regulate inflammation, hormone balance, and even mood. Furthermore, studies suggest that gut bacteria communicate with the brain through chemical messengers and neural pathways.
Consequently, maintaining balanced gut flora through diet, fiber, or a probiotic supplement supports overall health.
Bacteria and the Immune System
Interestingly, facts about bacteria reveal that microbes strengthen the immune system by training it to recognize invading pathogens. Moreover, exposure to harmless microbes in childhood helps the body learn the difference between safe and dangerous organisms. Because immune cells rely on bacterial signals, disruptions in gut flora may weaken defenses.
Additionally, beneficial bacteria act as a shield against harmful microbes by occupying space, producing natural antibiotics, and lowering pH levels. Furthermore, this relationship demonstrates how the human body and bacteria evolve together in a mutually supportive way. Consequently, awareness of these facts about bacteria encourages healthier lifestyle choices.
Pathogenic Bacteria and Disease
How Harmful Bacteria Spread
Although many bacteria are beneficial, other species cause illness. Moreover, these pathogenic bacteria spread through contaminated water, food, air, or physical contact. Because bacteria multiply rapidly, even small exposures may lead to infection.
Additionally, illnesses such as urinary tract infections, skin infection, pneumonia, and meningitis can be traced to specific microbes. Furthermore, environmental factors—such as poor hygiene, crowding, or warm temperatures—increase transmission risk. Consequently, public education about facts about bacteria remains vital for community safety.
Examples of Common Bacterial Diseases
Interestingly, several bacterial infections occur worldwide, including:
- E. coli infection
- Cholera
- Tuberculosis
- Strep throat
- MRSA (methicillin-resistant staphylococcus aureus)
- Whooping cough
Moreover, accurate diagnosis helps determine which type of bacteria is responsible. Because antibiotic resistance is increasing, medical teams rely on lab cultures, case histories, and medical records to choose effective treatment.
Additionally, early detection improves outcomes and prevents more severe complications. Consequently, public awareness of these facts about bacteria supports earlier intervention.
If you have some free time, it might be helpful to check out this article The Best 15 Interesting Facts About E.coli. It covers some relevant points.
The Role of Bacteria in Industry and Innovation
How Bacteria Benefit the Pharmaceutical Industry
Interestingly, surprising facts about bacteria show that they drive major advancements in medicine. Moreover, bacteria are used in the production of a wide variety of chemotherapeutics, vaccines, enzymes, and medical compounds. Because microbes adapt quickly, their natural defense chemicals help scientists develop new antibiotics to treat resistant infections.
Additionally, bacteria are used to test drugs, produce proteins, and create genetic tools for research. Furthermore, engineered bacterial strains help synthesize insulin, cancer treatments, and antiviral medications. Consequently, bacteria remain essential to the future of biotechnology.
Bacteria in Energy and Environmental Science
Interestingly, some bacteria contribute to the production of biofuel, breaking down agricultural waste or converting sugars into usable energy. Moreover, microbes that absorb toxins or metals help clean polluted ecosystems through bioremediation. Because bacteria break down complex materials, they serve as a primary role in recycling nutrients from soil, oceans, and dead plants.
Additionally, bacteria influence climate cycles, atmospheric gases, and long-term ecological balance. Furthermore, facts about bacteria reveal that microbes have shaped Earth’s evolution for billions of years. Consequently, these tiny organisms remain powerful forces in global sustainability.
Snippet Section: Quick Facts About Bacteria

What are the most important facts about bacteria?
Bacteria are unicellular organisms that exist everywhere on Earth, from the human body to hot springs, oceans, and soil. Moreover, they help the digestive system, support the immune system, and break down dead plants in nature.
Additionally, some bacteria cause illness, while others act as a great source of antibiotics. Because bacteria have different shapes, cell structures, and functions, they play essential roles in health, ecosystems, and industry.
The Future of Bacterial Research
New Species of Bacteria Are Still Being Discovered
Interestingly, many facts about bacteria show that new species continue to emerge. Moreover, scientists studying pond water, soil, and deep oceans frequently find microbes never seen before. Because bacteria evolve quickly through random mutations, their diversity expands constantly. Additionally, researchers believe that more than one-third of the total world bacterial species remain undiscovered.
Furthermore, these findings help scientists understand how microbes adapt to extreme conditions, contribute to ecosystems, and influence climate processes. Consequently, the discovery of new species of bacteria provides valuable insights into life’s complexity.
Bacteria May Unlock Future Medical Breakthroughs
Interestingly, facts about bacteria reveal enormous potential for future medicine. Moreover, engineered bacterial strains could one day treat genetic disorders or deliver targeted therapies. Because bacteria exchange DNA, they can be modified to carry beneficial genes or remove harmful substances from the body.
Additionally, genetic engineering tools derived from bacteria continue to transform biomedical science. Furthermore, future treatments may rely on bacteria to fight cancer, repair tissues, or prevent infection. Consequently, the study of bacteria remains one of the most promising fields in modern biology.
Facts About Bacteria: Frequently Asked Questions

What are the most surprising facts about bacteria?
Many surprising facts about bacteria include their ability to survive high temperatures, produce electrical signals, and communicate using chemicals. Moreover, bacteria influence weather, soil health, digestion, and immunity.
How do bacteria differ in shape and size?
Different types of bacteria display different shapes, including rods, spheres, and spirals. Moreover, the body length or length of a complete bacteria varies widely and often cannot be seen with the naked eye.
Why are some bacteria harmful?
Some bacteria become harmful when they invade tissues or release toxins. Moreover, pathogenic bacteria cause illnesses like pneumonia, urinary tract infections, and skin infection.
What is the best way to prevent bacterial infections?
The best way to prevent illness is through hand washing, food safety, vaccinations, and proper antibiotic use. Moreover, hygiene protects against invading pathogens and reduces bacterial resistance.
How do bacteria benefit the environment?
Bacteria support ecosystems by breaking down dead plants, producing nutrients, and recycling elements. Moreover, soil bacteria enrich farmland and help plants grow.
Facts About Bacteria Conclusion
Although bacteria are invisible, countless facts about bacteria reveal their immense power. Moreover, these microscopic organisms shape health, drive ecosystems, and fuel industrial innovations. Because bacteria act as recyclers, protectors, and sometimes threats, understanding them reduces fear and increases appreciation for their complexity.
Additionally, future discoveries in microbiology promise breakthroughs in medicines, clean energy, and environmental restoration. Furthermore, awareness of these facts about bacteria empowers people to make informed choices about hygiene, wellness, and the natural world.
Consequently, bacteria remain not only ancient survivors but also essential partners in shaping life on Earth.


